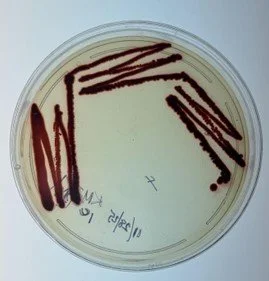
Unknown Lab Project Clinical Microbiology
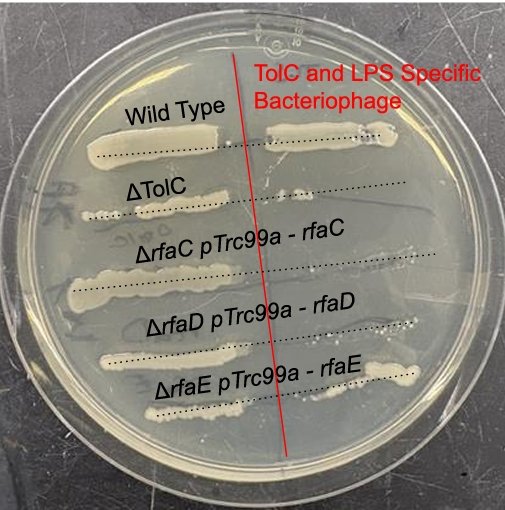
Lipopolysaccharide Biosynthesis in E. coli

Bachelor of Science, Biochemistry
Ambitious Biochemistry student who has a strong background in chemistry and biology, and extensive laboratory experience, including data analysis and molecular research. Enthusiastic about expanding pharmaceutical knowledge and developing the clinical and technical skills necessary to pursue a career as a pharmacist.
Work Experience
-
Walgreens Pharmacy (Current)
I assist pharmacists by stocking, labeling, maintaining records, processing prescriptions, and other duties as needed.
-
ProHealth Care (February 2020-July 2020)
I worked in the Oncology inpatient unit and helped the patients do all activities. I took vitals, help patients shower and go to the bathroom, do all ADLs, and more. I also worked with COVID-19 patients briefly and got experience working during a pandemic.
-
IT Help Desk Technician (August 2023 - May 2025)
Wisconsin Lutheran College
I took phone calls and fixed computers in classrooms with faculty and students based on their technological needs.
Lifeguard (June 2016-2019)
Ingleside Hotel
I had been taking care of duties at the waterpark such as surveying the area for primary medical issues, assisting in care of guests with medical emergencies, running the waterpark and arcade, and running in-service which consists of practicing skills such as CPR, AED, and First Aid. I worked as a leader of a team of Lifeguards, teaching and working together to learn skills.
Coursework
-
In this senior capstone course, I designed and performed research studying the kinetics of folding for the tetrahymena ribozyme using low levels of magnesium and chaperone proteins such as chymotrypsin. I transformed bacterial cultures with plasmids containing the gene for the ribozyme, isolated the gene, performed a DNA gel electrophoresis, translated the gene into the ribozyme, and studied the kinetics using a plate reader and fluorescence. This class helped me develop biological techniques to study molecules, data analysis, critical thinking, and scientific communication.
-
In this lab-based course, I created and performed an experiment to figure out the decay of gabapentin using nonaqueous titration to figure out the quantity of gabapentin in two different samples of the medication: a recently obtained batch and a sample previously kept in home from 2019. I also applied chemistry techniques such as acid-base and complexometric titration, UV-Vis spectroscopy, gas chromatography, and electrolysis, so that I could determine the different chemical compounds based on these properties and produce accurate and precise data.
-
In this course, I studied the structure, function, kinetics, and metabolic pathways of the biological macromolecules, and applied concepts of organic chemistry and biology. In lab, I learned to separate, detect, and modify biomolecules and used bioinformatic and computational techniques to assess this. The final project studied α-chymotrypsin catalysis of 4-nitrophenyl acetate in both pre-steady state and steady state using UV-vis. I learned to create a research article and analyze data using programs like Pymol, Desmos, KaleidaGraph, and KinTek Explorer.
-
In this course, I studied the growth, identification, and function of pathogens, and the way the human body reacts to these pathogens. I learned aseptic techniques to isolate, culture, and identify different pathogens using staining and growth mediums.
-
I studied how heredity works on a molecular level, including genetic systems, the structure and role of nucleic acids, mutations, and genes in development and population genetics. In lab, I amplified and cloned E. coli genes using PCR, restriction digest, ligation, and electroporation, and used gel electrophoresis to confirm results.
-
Anatomy & Physiology (lecture & lab) Cell Biology (lecture & lab); General Chemistry I & II (lecture & lab); Human Growth & Development; Intro to Psychology; Intro to Sociology; Issues & Ethics in Healthcare; Medical Terminology; Organic Chemistry I (lecture & lab); Physics for Health Professionals (lecture & lab); Physics II (lecture & lab); Principles of Biology I & II (lecture & lab)